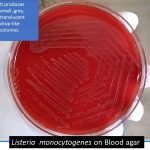
Listeria on blood agar and its colony morphology
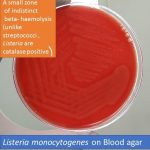
Listeria monocytogenes on Blood agar

Collection Group: Clinical Bacteriology
Klebsiella pneumoniae: Introduction,Morphology, Culture Characteristics, Pathogenecity, Lab Diagnosis and Treatment
 Introduction of Klebsiella pneumoniae Klebsiella pneumoniae gucose utilization test using Andrade's...
Introduction of Klebsiella pneumoniae Klebsiella pneumoniae gucose utilization test using Andrade's...
Listeria on Blood Agar: Introduction, Morphology, Culture Characteristics, Pathogenesis, Lab Diagnosis and Treatment
Introduction of Listeria Listeria monocytogenes on blood agar and its...
Introduction of Listeria Listeria monocytogenes on blood agar and its...
Listeria monocytogenes: Introduction, Morphology, Culture Characteristics, Pathogenesis, Lab Diagnosis and Treatment
Introduction of Listeria Monocytogenes Listeria monocytogenes on blood agar and its...
Introduction of Listeria Monocytogenes Listeria monocytogenes on blood agar and its...
